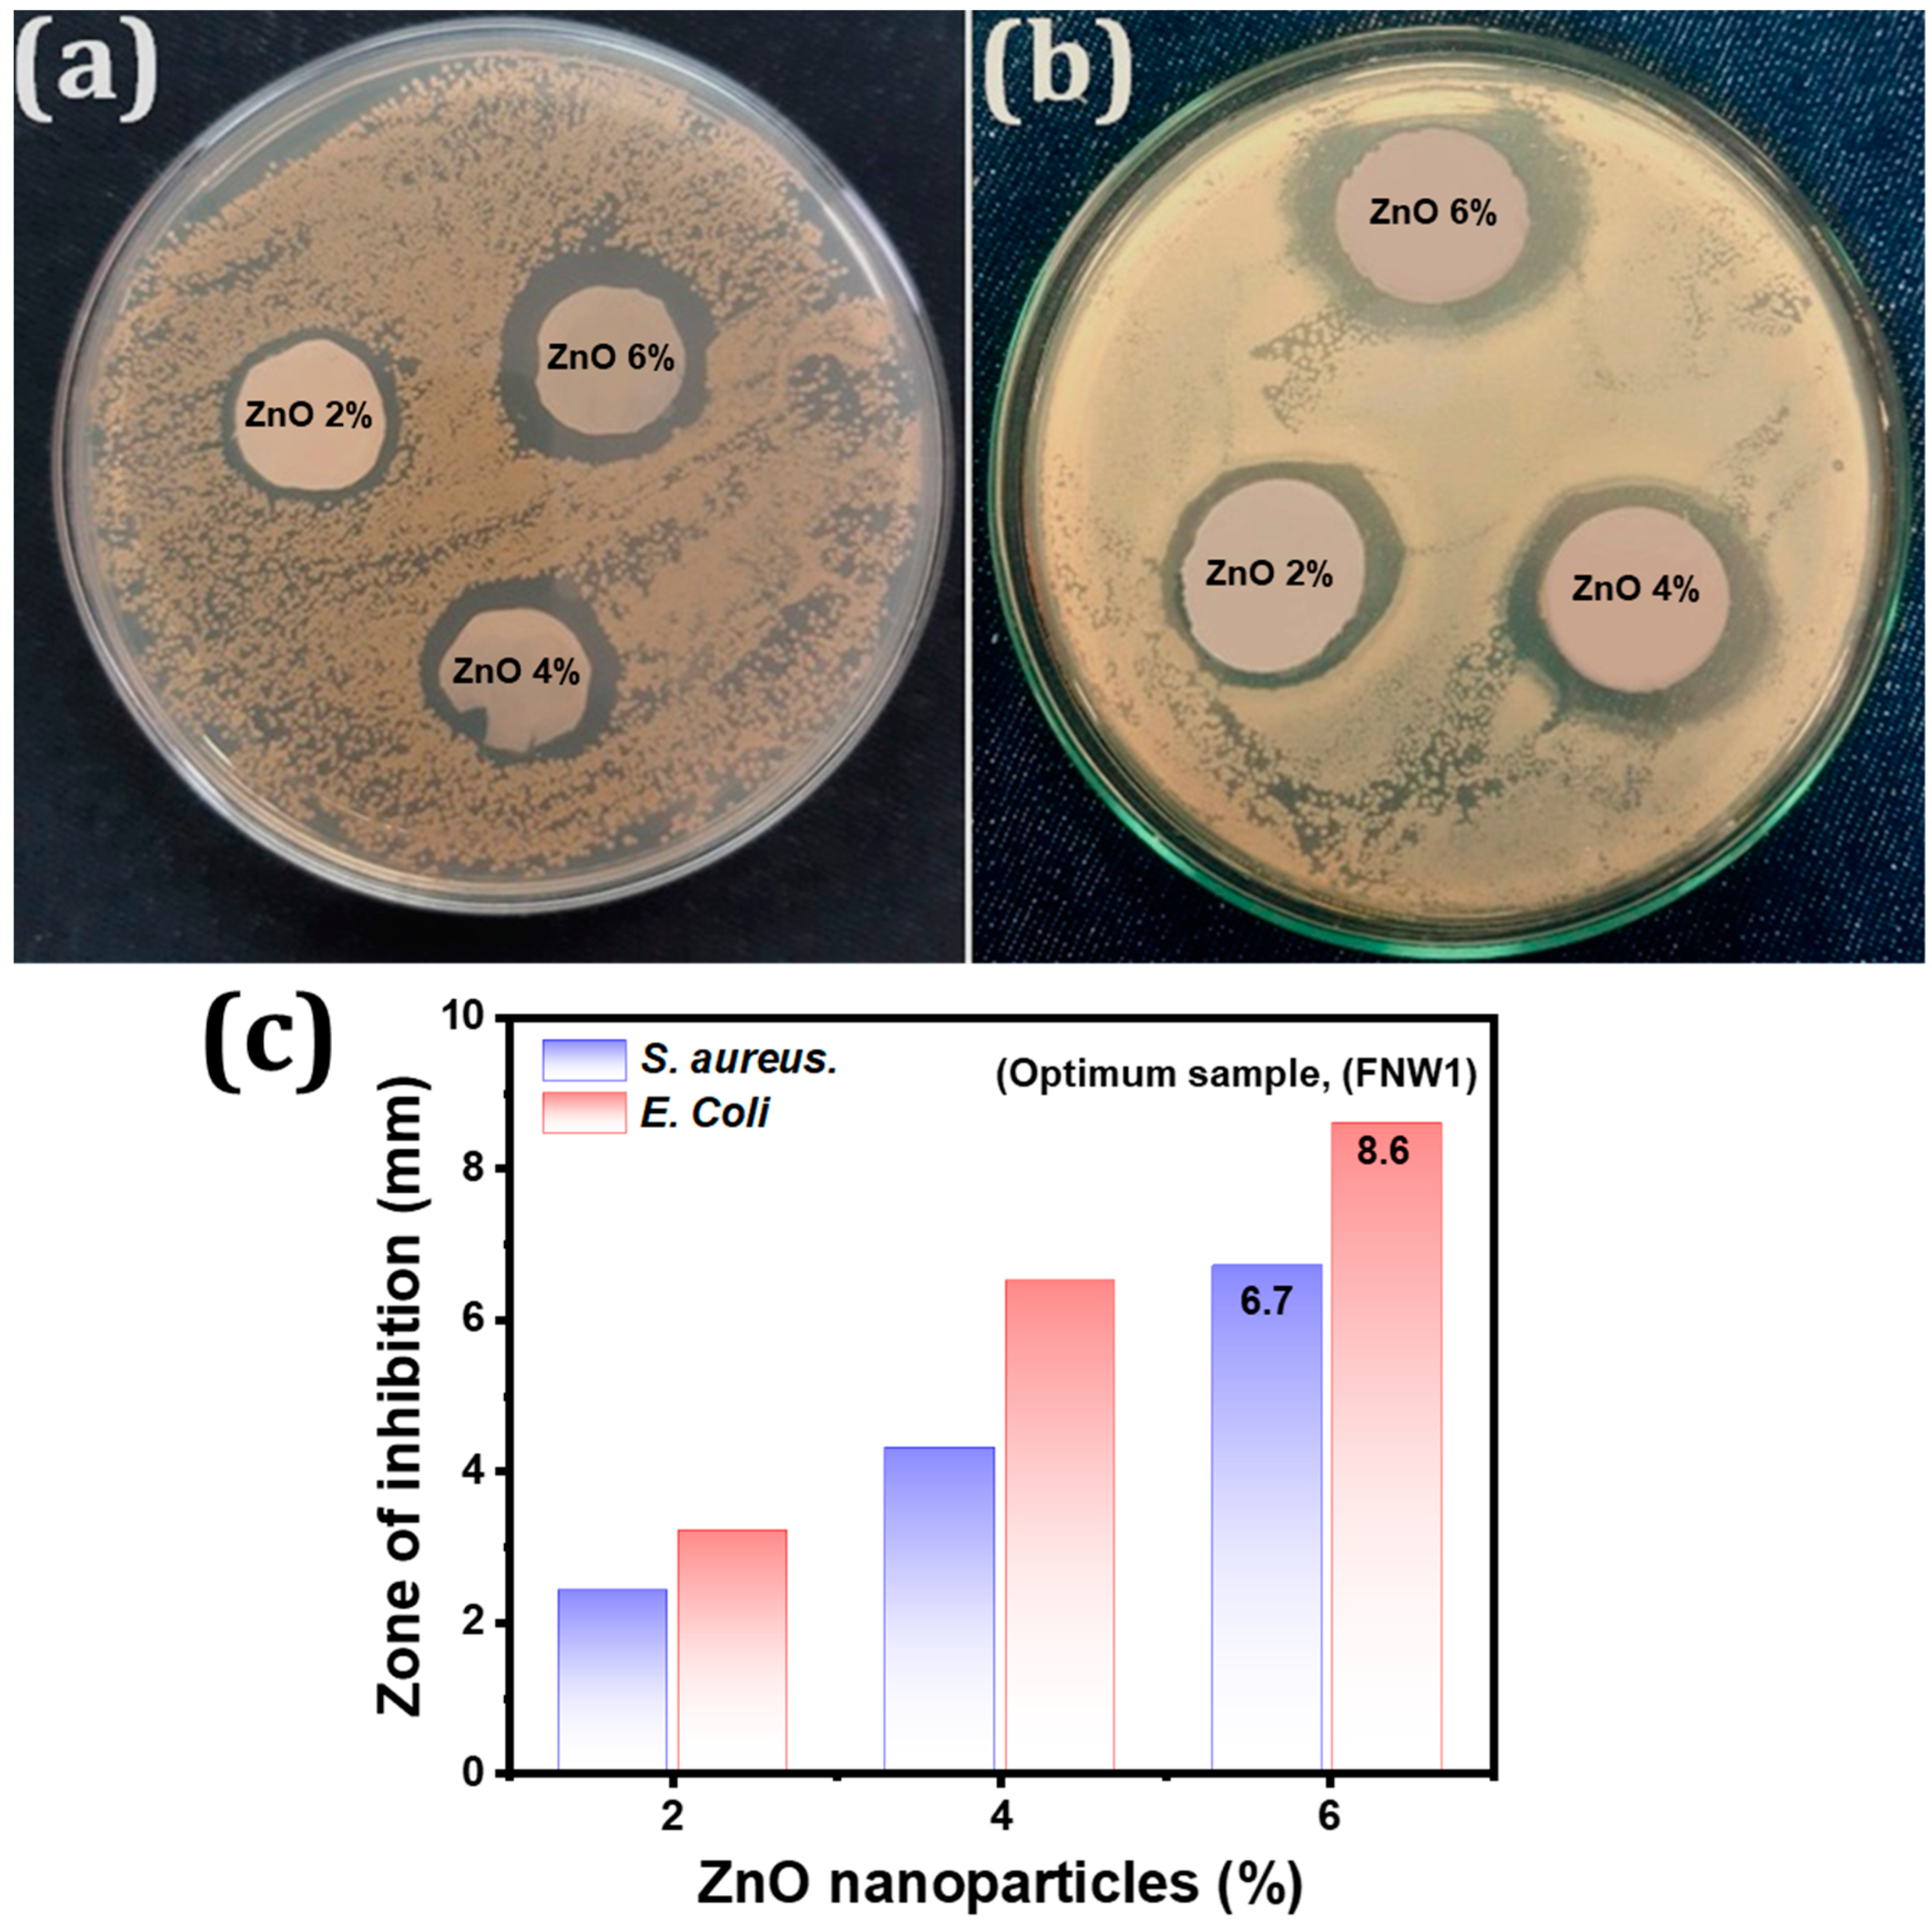
Membranes 12 01230 g006 Membranes 12 01230 g006

Nonwoven/Nanomembrane Composite Functional Sweat Pads
Abstract
1. Introduction
2. Materials and Methods
2.1. Development of A Functional Sweat Pad
2.2. Characterization and Techniques
3. Results and Discussions
3.1. Optimization of Nanofiber Fiber Morphology and Diameter
3.2. Regression Model for Phase I Parameters
3.3. Optimized PA-6 Nanofibers
3.4. Optimization of Nonwoven Layers through the Evaluation of Comfort Characteristics
3.5. Optimization of Functional Layers through the Antimicrobial Activity
3.6. Comfort Characteristics of Developed Sweat Pad
4. Conclusions
Author Contributions
Funding
Institutional Review Board Statement
Informed Consent Statement
Data Availability Statement
Acknowledgments
Conflicts of Interest
References
- Srikrishnan, M. Design and Development of Under Arm Sweat Pad. In Sustainable Approaches in Textiles and Fashion; Springer: Heidelberg, Germany, 2022; pp. 219–250. [Google Scholar]
- Legner, C.; Kalwa, U.; Patel, V.; Chesmore, A.; Pandey, S. Sweat sensing in the smart wearables era: Towards integrative, multifunctional and body-compliant perspiration analysis. Sens. Actuators A Phys. 2019, 296, 200–221. [Google Scholar] [CrossRef]
- Ali, M.; Zeeshan, M.; Ahmed, S.; Qadir, B.; Nawab, Y.; Anjum, A.S.; Riaz, R. Development and comfort characterization of 2D-woven auxetic fabric for wearable and medical textile applications. Cloth. Text. Res. J. 2018, 36, 199–214. [Google Scholar] [CrossRef]
- Ge, J.-L.; Wang, J.-X.; Wu, C.-C.; Bao, L.-J.; Zeng, E.Y. Development of an in vitro model to simulate migration of organic contaminants from pad products to human sweat and enhance dermal exposure risk assessment. Sci. Total Environ. 2021, 795, 148827. [Google Scholar] [CrossRef] [PubMed]
- Mushtaq, B.; Ahmad, A.; Ali, Z.; Qadir, M.B.; Khaliq, Z.; Irfan, M.; Iqbal, M.W.; Jabbar, A.; Zulifqar, A.; Shahzad, A. Core Spun Based Helical Auxetic Yarn: A Novel Structure for Wearable Protective Textiles. J. Nat. Fibers 2022, 19, 15058–15070. [Google Scholar] [CrossRef]
- Kaplan, S.; Aslan, S. Subjective wear trials to evaluate thermal comfort of the foot clothing system including a sweat pad. J. Text. Inst. 2017, 108, 1340–1349. [Google Scholar] [CrossRef]
- Schmidt-Rose, T.; Lehmbeck, F.; Bürger, A.; Windisch, B.; Keyhani, R.; Max, H. Efficient sweat reduction of three different antiperspirant application forms during stress-induced sweating. Int. J. Cosmet. Sci. 2013, 35, 622–631. [Google Scholar] [CrossRef]
- de Groot, J.H.; Kirk, P.A.; Gottfried, J.A. Encoding fear intensity in human sweat. Philos. Trans. R. Soc. B 2020, 375, 20190271. [Google Scholar] [CrossRef]
- Nyein, H.Y.Y.; Bariya, M.; Tran, B.; Ahn, C.H.; Brown, B.J.; Ji, W.; Davis, N.; Javey, A. A wearable patch for continuous analysis of thermoregulatory sweat at rest. Nat. Commun. 2021, 12, 1823. [Google Scholar] [CrossRef] [PubMed]
- Klous, L.; de Ruiter, C.; Alkemade, P.; Daanen, H.; Gerrett, N. Sweat rate and sweat composition following active or passive heat re-acclimation: A pilot study. Temperature 2020, 8, 90–104. [Google Scholar] [CrossRef]
- Zhao, Y.; Wang, X.; Wang, D.; Li, H.; Li, L.; Zhang, S.; Zhou, C.; Zheng, X.; Men, Q.; Zhong, J.; et al. Preparation and Chemical Protective Clothing Application of PVDF Based Sodium Sulfonate Membrane. Membranes 2020, 10, 190. [Google Scholar] [CrossRef] [PubMed]
- Gikunda, M.N.; Harerimana, F.; Mangum, J.M.; Rahman, S.; Thompson, J.P.; Harris, C.T.; Churchill, H.O.; Thibado, P.M. Array of Graphene Variable Capacitors on 100 mm Silicon Wafers for Vibration-Based Applications. Membranes 2022, 12, 533. [Google Scholar] [CrossRef]
- Coull, N.A.; West, A.M.; Hodder, S.G.; Wheeler, P.; Havenith, G. Body mapping of regional sweat distribution in young and older males. Eur. J. Appl. Physiol. 2021, 121, 109–125. [Google Scholar] [CrossRef]
- Sun, K.C.; Arbab, A.A.; Sahito, I.A.; Qadir, M.B.; Choi, B.J.; Kwon, S.C.; Yeo, S.Y.; Yi, S.C.; Jeong, S.H. A PVdF-based electrolyte membrane for a carbon counter electrode in dye-sensitized solar cells. RSC Adv. 2017, 7, 20908–20918. [Google Scholar] [CrossRef]
- Mignon, A.; Vermeulen, J.; Snoeck, D.; Dubruel, P.; Van Vlierberghe, S.; De Belie, N. Mechanical and self-healing properties of cementitious materials with pH-responsive semi-synthetic superabsorbent polymers. Mater. Struct. 2017, 50, 238. [Google Scholar] [CrossRef]
- Lalitha, P.; Jayanthi, P.; Sujitha, R. Antimicrobial Activity of Perspiration Pads and Cotton Cloth Fabricated with the Ethyl Acetate Extract of Eichhornia crassipes (Mart.) Solms. J. Text. 2014, 2014, 943287. [Google Scholar] [CrossRef]
- Yu, H.; Sun, J. Sweat detection theory and fluid driven methods: A review. Nanotechnol. Precis. Eng. 2020, 3, 126–140. [Google Scholar] [CrossRef]
- Goh, L.M.; Thong, Z.; Li, W.P.; Ooi, S.T.; Esa, F.; Ng, K.S.; Dhalla, A.; Gudipati, C. Development and Industrial-Scale Fabrication of Next-Generation Low-Energy Membranes for Desalination. Membranes 2022, 12, 540. [Google Scholar] [CrossRef] [PubMed]
- Aksoy, A.; Kaplan, S. Production and performance analysis of an antibacterial foot sweat pad. Fibers Polym. 2013, 14, 316–323. [Google Scholar] [CrossRef]
- Dunn, A.M.; Hofmann, O.S.; Waters, B.; Witchel, E. Cloaking malware with the trusted platform module. In Proceedings of the 20th USENIX Security Symposium (USENIX Security 11), San Francisco, CA, USA, 8–12 August 2011. [Google Scholar]
- West, A.M.; Tarrier, J.; Hodder, S.; Havenith, G. Sweat distribution and perceived wetness across the human foot: The effect of shoes and exercise intensity. Ergonomics 2019, 62, 1450–1461. [Google Scholar] [CrossRef]
- Smith, C.J.; Havenith, G. Upper body sweat mapping provides evidence of relative sweat redistribution towards the periphery following hot-dry heat acclimation. Temperature 2019, 6, 50–65. [Google Scholar] [CrossRef]
- Raccuglia, M.; Pistak, K.; Heyde, C.; Qu, J.; Mao, N.; Hodder, S.; Havenith, G. Human wetness perception of fabrics under dynamic skin contact. Text. Res. J. 2018, 88, 2155–2168. [Google Scholar] [CrossRef]
- Zong, X.; Kim, K.; Fang, D.; Ran, S.; Hsiao, B.S.; Chu, B. Structure and process relationship of electrospun bioabsorbable nanofiber membranes. Polymer 2002, 43, 4403–4412. [Google Scholar] [CrossRef]
- Khanzada, H.; Salam, A.; Qadir, M.B.; Phan, D.-N.; Hassan, T.; Munir, M.U.; Pasha, K.; Hassan, N.; Khan, M.Q.; Kim, I.S. Fabrication of promising antimicrobial aloe vera/PVA electrospun nanofibers for protective clothing. Materials 2020, 13, 3884. [Google Scholar] [CrossRef] [PubMed]
- Alemany, M.; Keirat, C. Breathable Perspiration Pads Having Odor Control. U.S. Patent 6,203,810, 20 March 2001. [Google Scholar]
- Corzani, I.; Romano, M. Disposable Absorbent Article for Topical Adhesive Attachment to the Skin of a Wearer. U.S. Patent 6,316,524, 13 November 2001. [Google Scholar]
- Ahmad, A.; Ali, U.; Nazir, A.; Shahzad, A.; Khaliq, Z.; Qadir, M.B.; Khan, M.A.; Ali, S.; Aamir Hassan, M.; Abid, S.; et al. Toothed wheel needleless electrospinning: A versatile way to fabricate uniform and finer nanomembrane. J. Mater. Sci. 2019, 54, 13834–13847. [Google Scholar] [CrossRef]
- Karbakhsh, H. Armpit Perspiration Absorbing Pad. U.S. Patent US15/474,051, 4 October 2018. [Google Scholar]
- Jalalah, M.; Ahmad, A.; Saleem, A.; Qadir, M.B.; Khaliq, Z.; Khan, M.Q.; Nazir, A.; Faisal, M.; Alsaiari, M.; Irfan, M.; et al. Electrospun Nanofiber/Textile Supported Composite Membranes with Improved Mechanical Performance for Biomedical Applications. Membranes 2022, 12, 1158. [Google Scholar] [CrossRef] [PubMed]
- Javaid, A.; Jalalah, M.; Safdar, R.; Khaliq, Z.; Qadir, M.B.; Zulfiqar, S.; Ahmad, A.; Satti, A.N.; Ali, A.; Faisal, M.; et al. Ginger Loaded Polyethylene Oxide Electrospun Nanomembrane: Rheological and Antimicrobial Attributes. Membranes 2022, 12, 1148. [Google Scholar] [CrossRef]
- He, X.; Shi, J.; Hao, Y.; He, M.; Cai, J.; Qin, X.; Wang, L.; Yu, J. Highly stretchable, durable, and breathable thermoelectric fabrics for human body energy harvesting and sensing. Carbon Energy 2022, 4, 621–632. [Google Scholar] [CrossRef]
- Ahmad, A.; Khan, M.A.; Nazir, A.; Arshad, S.N.; Qadir, M.B.; Khaliq, Z.; Khan, Z.S.; Satti, A.N.; Mushtaq, B.; Shahzad, A. Triaxial electrospun mixed-phased TiO2 nanofiber-in-nanotube structure with enhanced photocatalytic activity. Microporous Mesoporous Mater. 2021, 320, 111104. [Google Scholar] [CrossRef]
- Khan, M.A.; Ahmad, A.; Arshad, S.N.; Nazir, A.; Ahmad, S.; Khan, M.Q.; Shahzad, A.; Satti, A.N.; Qadir, M.B.; Khaliq, Z. Development of optimized triaxially electrospun titania nanofiber-in-nanotube core-shell structure. J. Appl. Polym. Sci. 2021, 138, 50562. [Google Scholar] [CrossRef]
- He, X.; Shi, J.; Hao, Y.; Wang, L.; Qin, X.; Yu, J. PEDOT:PSS/CNT composites based ultra-stretchable thermoelectrics and their application as strain sensors. Compos. Commun. 2021, 27, 100822. [Google Scholar] [CrossRef]
- Liu, Y.; Xiong, J.; Li, A.; Wang, R.; Wang, L.; Qin, X. Plasmonic silver nanoparticle-decorated electrospun nanofiber membrane for interfacial solar vapor generation. Text. Res. J. 2021, 91, 2624–2634. [Google Scholar] [CrossRef]
- Wulf, K.; Senz, V.; Eickner, T.; Illner, S. Water uptake of various electrospun nonwovens. Curr. Dir. Biomed. Eng. 2020, 6, 155–158. [Google Scholar] [CrossRef]
- Aziz, F.M.; Aziz, A.; Surip, S.; Ahmad, N.; Khairun, M.; Uyup, M.K.A.; Mou’ad, A.; Tarawneh, M.; Lee, S.H. Evaluation of wetting, structural and thermal properties of electrospun nanofibers at different pineapple leaf fiber/polyethylene terephthalate ratios. Maderas Cienc. Tecnol. 2021, 23, 1–12. [Google Scholar] [CrossRef]

| Sample Code | Concentration (%) | Voltage (kV) | Flow Rate (µL/h) |
|---|---|---|---|
| NF1 | 18 | 30 | 150 |
| NF2 | 18 | 28 | 200 |
| NF3 | 18 | 32 | 200 |
| NF4 | 16 | 32 | 250 |
| NF5 | 16 | 28 | 150 |
| NF6 | 18 | 30 | 250 |
| NF7 | 14 | 30 | 250 |
| NF8 | 14 | 32 | 200 |
| NF9 | 16 | 30 | 200 |
| NF10 | 14 | 28 | 200 |
| NF11 | 16 | 30 | 200 |
| NF12 | 14 | 30 | 150 |
| NF13 | 16 | 28 | 250 |
| NF14 | 16 | 32 | 150 |
| NF15 | 16 | 30 | 200 |
| Sr | Diameter (nm) | Porosity (%) | Air Permeability (mm/s) | Thermal Resistance (m2 K/W) | OMMC | WVP (g/m2/Day) |
|---|---|---|---|---|---|---|
| Optimized NF12 | 180 ± 29 | 62.17 | 398 | 0.062 | 0.85 | 1065 |
| Sample Code | Coolmax (%) | Polypropylene (%) |
|---|---|---|
| NW1 | 100 | 0 |
| NW2 | 90 | 10 |
| NW3 | 75 | 25 |
| NW4 | 60 | 40 |
| NW5 | 50 | 50 |
| NW6 | 40 | 60 |
| NW7 | 25 | 75 |
| NW8 | 10 | 90 |
| NW9 | 0 | 100 |
| Sr | Air Permeability(mm/s) | Thermal Resistance(m2 K/W) | OMMC | WVP(g/m2/Day) |
|---|---|---|---|---|
| Nonwoven sample (NW1) | 398 | 0.062 | 0.85 | 1065 |
| Sr | Air Permeability (mm/s) | Thermal Resistance (m2 K/W) | OMMC | WVP (g/m2/Day) |
|---|---|---|---|---|
| Nonwoven sample (NW1) | 719 | 0.041 | 0.74 | 719.38 |
Publisher’s Note: MDPI stays neutral with regard to jurisdictional claims in published maps and institutional affiliations. |
© 2022 by the authors. Licensee MDPI, Basel, Switzerland. This article is an open access article distributed under the terms and conditions of the Creative Commons Attribution (CC BY) license (https://creativecommons.org/licenses/by/4.0/).
Share and Cite
Qadir, M.B.; Jalalah, M.; Shoukat, M.U.; Ahmad, A.; Khaliq, Z.; Nazir, A.; Anjum, M.N.; Rahman, A.; Khan, M.Q.; Tahir, R.; et al. Nonwoven/Nanomembrane Composite Functional Sweat Pads. Membranes 2022, 12, 1230. https://doi.org/10.3390/membranes12121230
Qadir MB, Jalalah M, Shoukat MU, Ahmad A, Khaliq Z, Nazir A, Anjum MN, Rahman A, Khan MQ, Tahir R, et al. Nonwoven/Nanomembrane Composite Functional Sweat Pads. Membranes. 2022; 12(12):1230. https://doi.org/10.3390/membranes12121230
Chicago/Turabian StyleQadir, Muhammad Bilal, Mohammed Jalalah, Muhammad Usman Shoukat, Adnan Ahmad, Zubair Khaliq, Ahsan Nazir, Muhammad Naveed Anjum, Abdul Rahman, Muhammad Qamar Khan, Rizwan Tahir, and et al. 2022. "Nonwoven/Nanomembrane Composite Functional Sweat Pads" Membranes 12, no. 12: 1230. https://doi.org/10.3390/membranes12121230
APA StyleQadir, M. B., Jalalah, M., Shoukat, M. U., Ahmad, A., Khaliq, Z., Nazir, A., Anjum, M. N., Rahman, A., Khan, M. Q., Tahir, R., Faisal, M., Alsaiari, M., Irfan, M., Alsareii, S. A., & Harraz, F. A. (2022). Nonwoven/Nanomembrane Composite Functional Sweat Pads. Membranes, 12(12), 1230. https://doi.org/10.3390/membranes12121230

